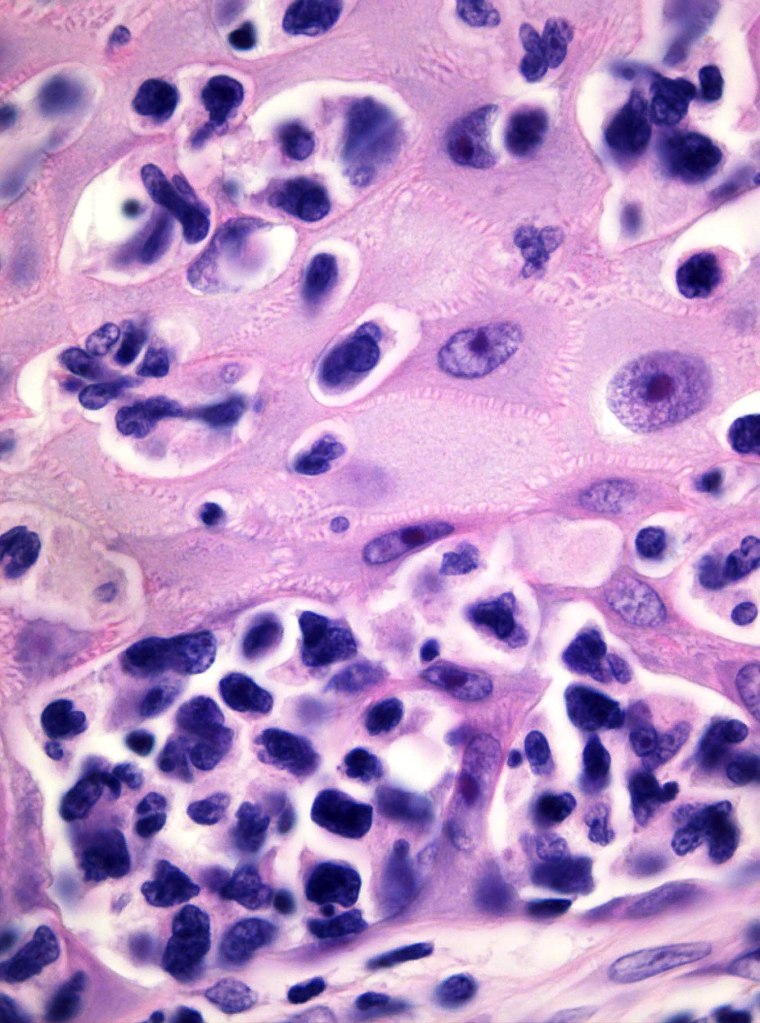
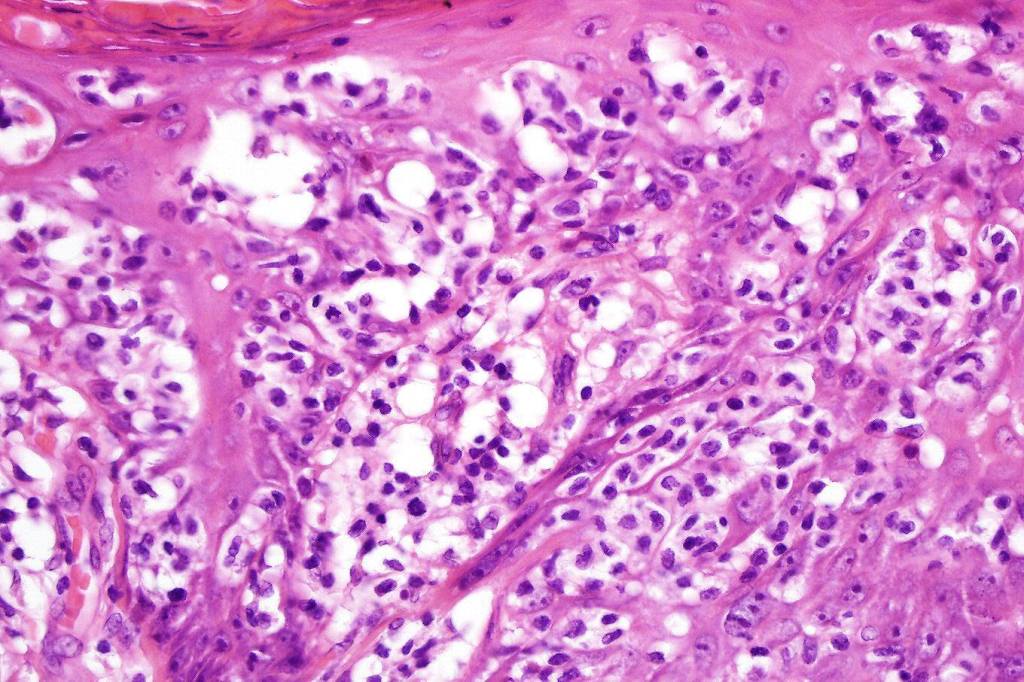
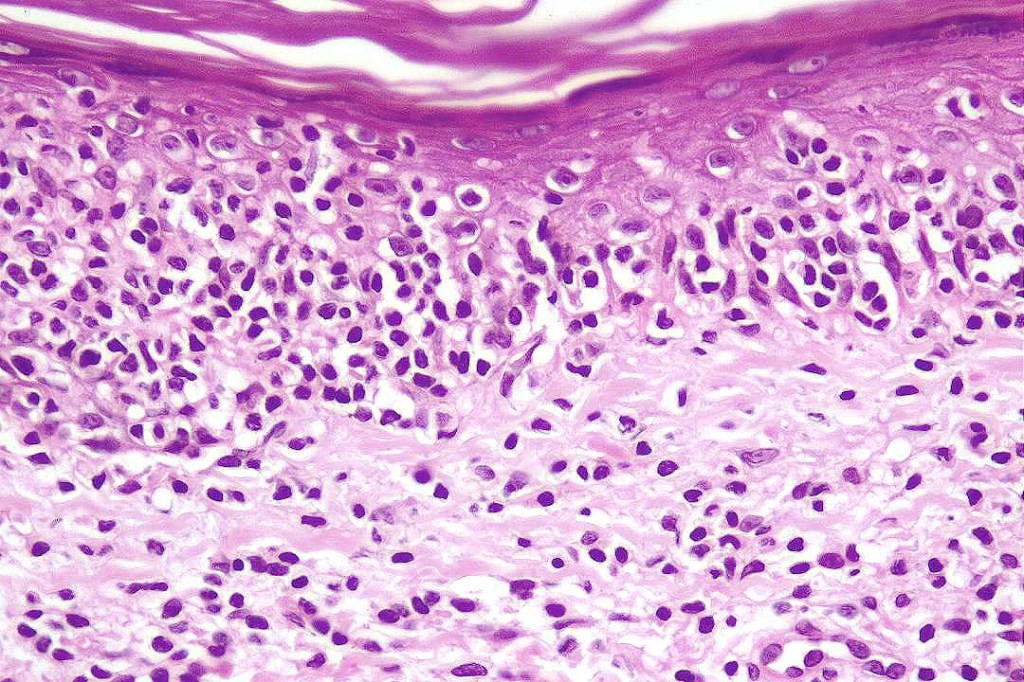
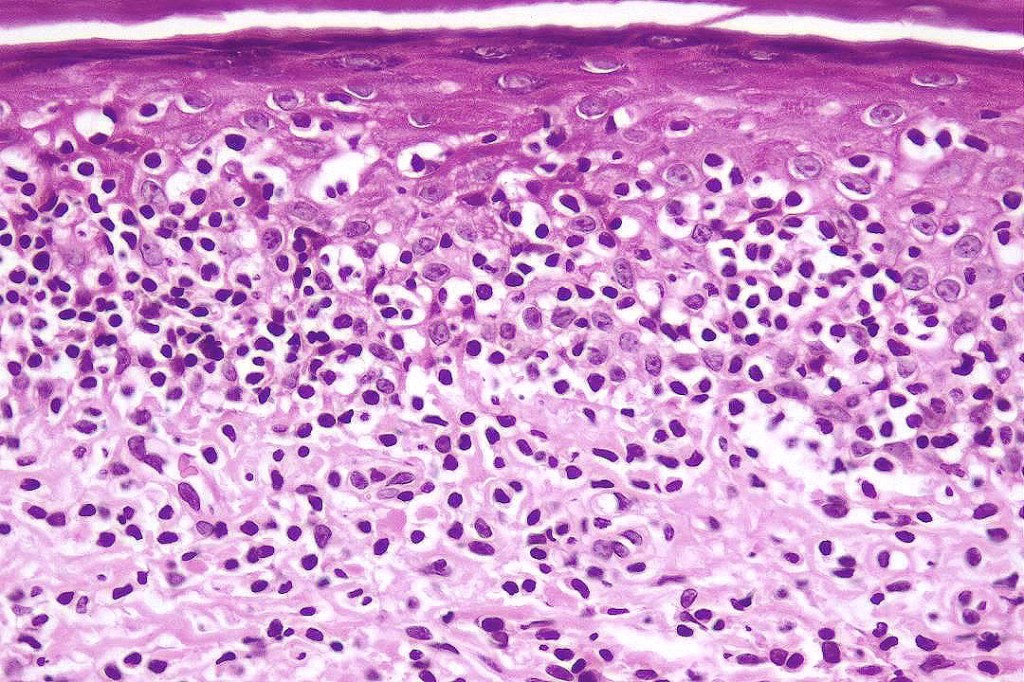

In the older literature, the condition was divided into localized disease (Woringer-Kolopp disease) and generalized disease (Ketron-Goodman disease). Nowadays, the latter is thought to represent a variety of lympohmas including epidermotropic CD8-positive cutaneous T-cell lymphoma, cutaneous γ/δ T cell lymphoma and mycosis fungoides.
Clinical features
•Very rare indolent form of CTL classified as a variant of MF
•Presents as a solitary, slowly growing, scaly, sharply delineated erythematous lesion
•Up to 30.0 cm diameter
•Predilection for the lower legs but can present elsewhere
Histological features
•Hyperkeratosis/parakeratosis
•Acanthosis often psoriasiform
•Very marked epidermotropic infiltrate of atypical lymphocytes including Sézary cells
•Perinuclear halo often present
•Pautrier-like microabscesses
•Variable mitotic activity
•Adnexal involvement
•Superficial dermal perivascular lymphohistiocytic infiltrate with only sparse or absent atypical forms
•CD45, CD2, CD3, CD5
•CD7 often reduced or lost
•CD4+ve or CD8+ve variants
•Variable CD30 & Ki-67 expression
•Monoclonal TCR

Leave a comment